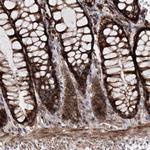
DAD1 Antibody in Immunohistochemistry (Paraffin) (IHC (P))

Search
Invitrogen
DAD1 Polyclonal Antibody
{{$productOrderCtrl.translations['antibody.pdp.commerceCard.promotion.promotions']}}
{{$productOrderCtrl.translations['antibody.pdp.commerceCard.promotion.viewpromo']}}
{{$productOrderCtrl.translations['antibody.pdp.commerceCard.promotion.promocode']}}: {{promo.promoCode}} {{promo.promoTitle}} {{promo.promoDescription}}. {{$productOrderCtrl.translations['antibody.pdp.commerceCard.promotion.learnmore']}}
产品信息
PA5-56003
种属反应
宿主/亚型
分类
类型
抗原
偶联物
形式
浓度
规格
纯化类型
保存液
内含物
保存条件
运输条件
RRID
产品详细信息
Immunogen sequence: MSASVVSVIS RFLEEYLSST PQRLKLLD
Highest antigen sequence identity to the following orthologs: Mouse - 100%, Rat - 100%.
靶标信息
Defender of cell death 1 (DAD1) was initially discovered in BHK21 cells as a negative regulator of programmed cell death, a process important for normal organism development and tissue homeostasis. DAD1 was later shown to be a subunit of the mammalian oligosaccharyltransferase complex and is required for its function and structural integrity. Mice lacking DAD1 express abnormal N-linked glycoproteins and undergo increased apoptotic-associated embryonic death. Furthermore, overexpression of DAD1 mRNA is seen in some human hepatocellular carcinomas, indicating it may also play a role in carcinogenesis. It should be noted that DAD1 is not related to the inhibitor of apoptosis proteins (IAP) family and does not contain any baculoviral IAP repeat (BIR) domains.
仅用于科研。不用于诊断过程。未经明确授权不得转售。
篇参考文献 (0)
生物信息学
蛋白别名: DAD-1; DAD1; Defender against cell death 1; Dolichyl-diphosphooligosaccharide--protein glycosyltransferase subunit DAD1; Oligosaccharyl transferase subunit DAD1; oligosaccharyltransferase 2 homolog; oligosaccharyltransferase subunit 2 (non-catalytic)
基因别名: DAD1; OST2
UniProt ID: (Human) P61803
Entrez Gene ID: (Human) 1603